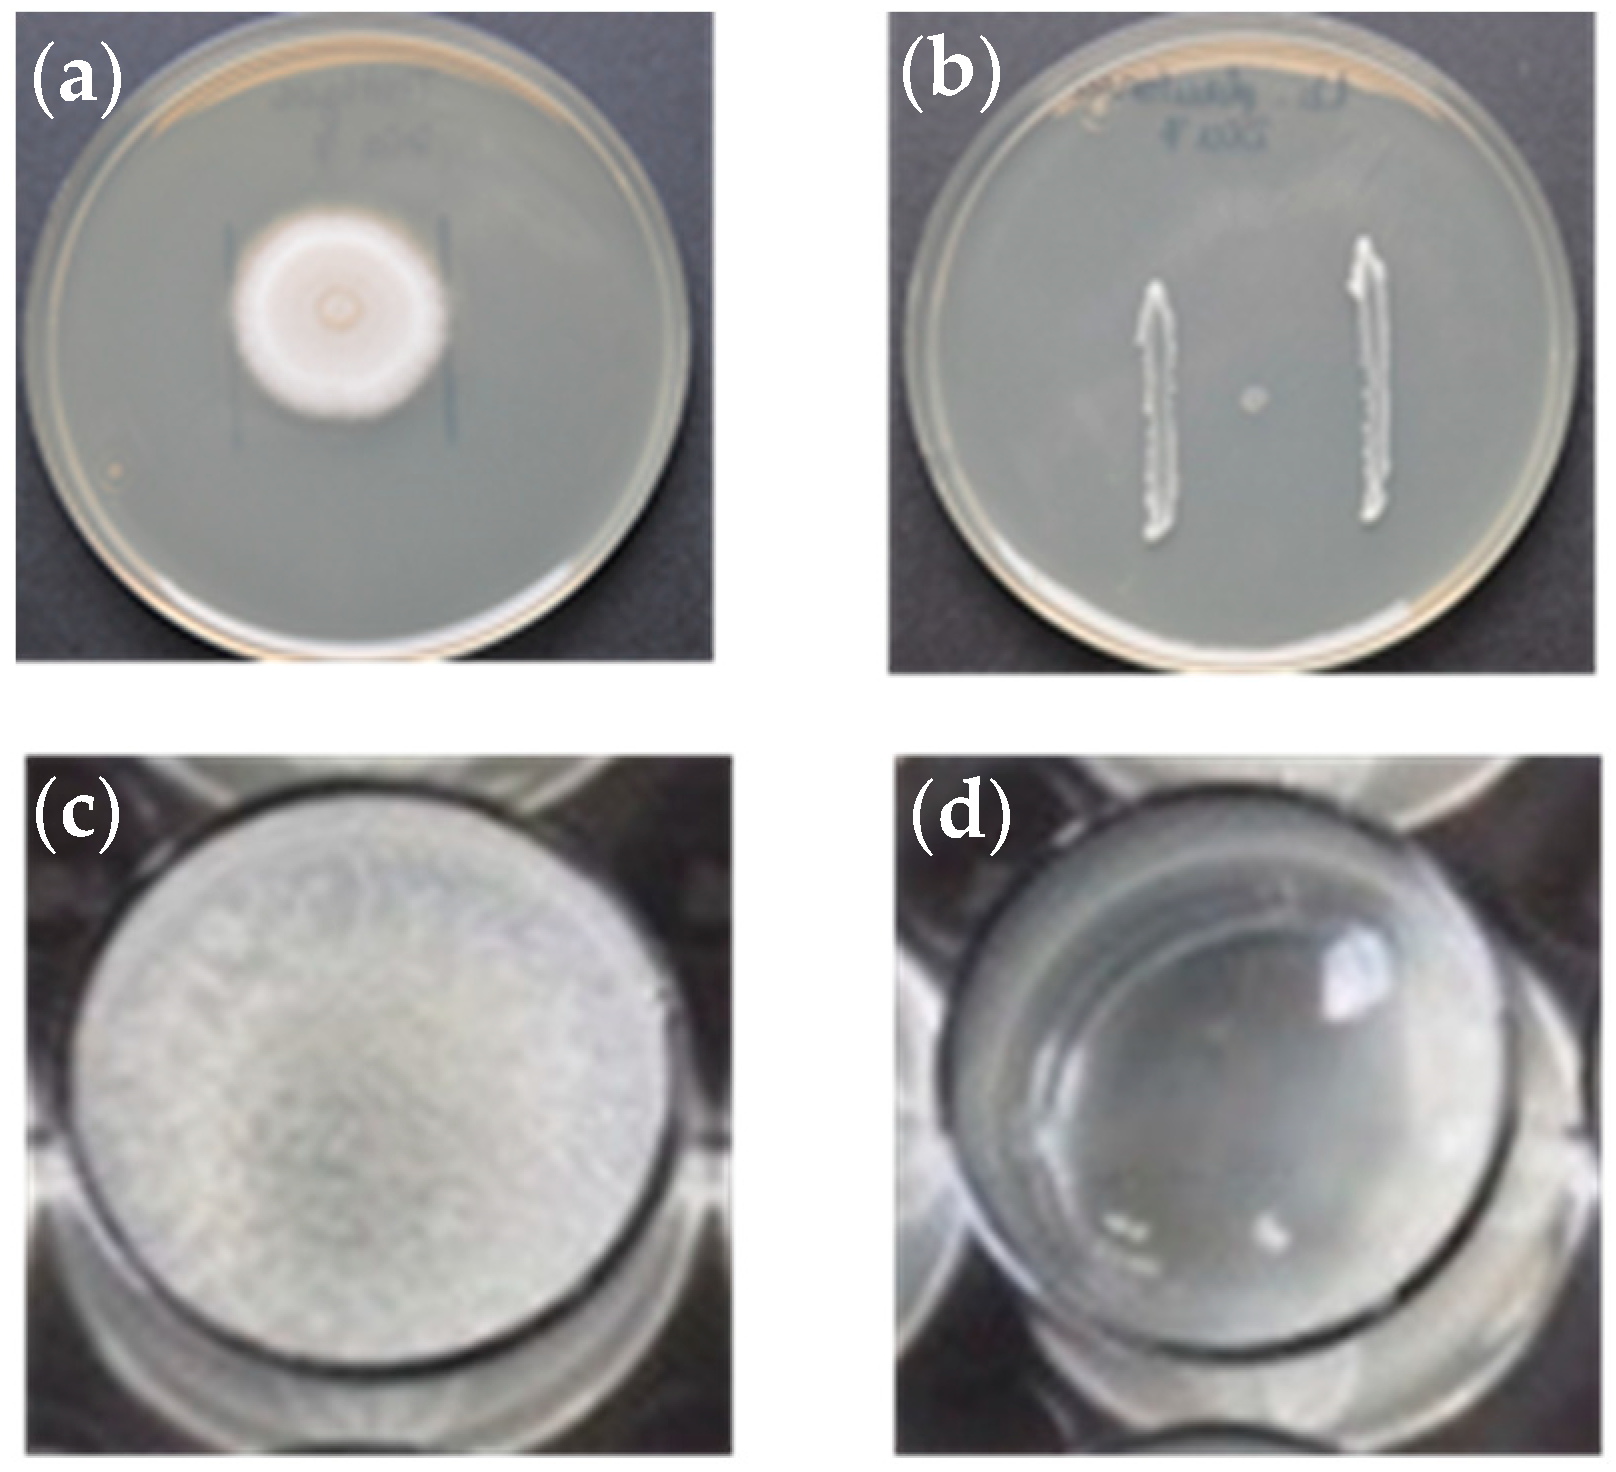
Animals 13 00954 g001 Animals 13 00954 g001

Limited Probiotic Effect of Enterococcus gallinarum L1, Vagococcus fluvialis L21 and Lactobacillus plantarum CLFP3 to Protect Rainbow Trout against Saprolegniosis
Abstract
Simple Summary
Abstract
1. Introduction
2. Materials and Methods
2.1. Collection of Isolates Used in the Study
2.2. In Vitro Inhibition Assays of the Probiotic Bacteria against S. parasitica
2.2.1. Inhibition of Hyphal Growth on Solid Media (Plate Assay)
2.2.2. Inhibition of Hyphal Growth from Colonized Hemp Seeds and Cyst Germination in Liquid Media
2.2.3. Assay to Evaluate Fungicidal Effects
2.2.4. Inhibition Assays with Bacterial Culture Supernatants
2.3. Adhesion to Skin Mucus of the Probiotic Bacteria and Inhibition of S. parasitica Cyst Adhesion
2.3.1. Adhesion to Skin Mucus of the Probiotic Bacteria
2.3.2. Inhibition of S. parasitica Cyst Adhesion
2.3.3. Statistical Analysis
2.4. Pathogenicity for Rainbow Trout
2.5. Biocontrol of Saprolegniosis by Adding Bacteria to Water or Feed
2.5.1. Biocontrol by Adding Bacteria to Water
2.5.2. Biocontrol by Adding Bacteria to Feed
2.5.3. Statistical Analysis
3. Results
3.1. In Vitro Inhibition Assays of the Probiotic Bacteria against S. parasitica
3.1.1. Assays with solid medium
3.1.2. Assays with Broth Medium (Hemp Seed Test and Cyst Test)
3.1.3. Fungicidal Effect of the Bacteria
3.1.4. Assays with Supernatants
3.2. Adhesion to Skin Mucus of the Probiotic Bacteria and Inhibition of S. parasitica Cyst Adhesion
3.3. Pathogenicity for Rainbow Trout
3.4. Biocontrol of Saprolegniosis by Adding the Bacteria to Water or Feed
4. Discussion
5. Conclusions
Author Contributions
Funding
Institutional Review Board Statement
Informed Consent Statement
Data Availability Statement
Acknowledgments
Conflicts of Interest
References
- Van Der Berg, A.H.; McLaggan, D.; Dieguez-Uribeondo, J.; Van West, P. The impact of the water moulds Saprolegnia diclina and Saprolegnia parasitica on natural ecosystems and the aquaculture industry. Fungal Biol. Rev. 2013, 27, 33–42. [Google Scholar] [CrossRef]
- Willoughby, L.G.; Roberts, R.J. Towards strategy use of fungicides against Saprolegnia parasitica in salmonid fish hatcheries. J. Fish Dis. 1992, 15, 1–13. [Google Scholar] [CrossRef]
- Scherier, T.M.; Rach, J.J.; Howe, E. Efficacy of formalin. hydrogen peroxide. and sodium chloride on fungal-infected rainbow trout eggs. Aquaculture 1996, 140, 323–331. [Google Scholar] [CrossRef]
- Kitancharoen, N.; Yamamoto, A.; Hatai, K. Fungicidal effect of hydrogen peroxide on fungal infection of rainbow trout eggs. Mycoscience 1997, 38, 375–378. [Google Scholar] [CrossRef]
- Forneris, G.; Bellardi, S.; Palmegiano, G.B.; Saroglia, M.; Sicuro, B.; Gasco, L.; Zoccarato, I. The use of ozone in trout hatchery to reduce saprolegniasis incidence. Aquaculture 2003, 221, 157–166. [Google Scholar] [CrossRef]
- Zhang, J.; Chen, J.; Huang, Q.; MacKinnon, B.; Nekouei, O.; Liu, H.; Jia, P.; Wang, J.; Li, N.; Huang, L.; et al. Copper/Carbon Core/Shell Nanoparticles: A Potential Material to Control the Fish Pathogen Saprolegnia parasitica. Front. Vet. Sci. 2021, 8, 689085. [Google Scholar] [CrossRef] [PubMed]
- Ibrahim, R.E.; Elshopakey, G.E.; Abd El-Rahman, G.I.; Ahmed, A.I.; Altohamy, D.E.; Zaglool, A.W.; Younis, E.M.; Abdelwarith, A.A.; Davies, S.J.; Al-Harthi, H.F.; et al. Palliative role of colloidal silver nanoparticles synthetized by moringa against Saprolegnia spp. infection in Nile Tilapia: Biochemical, immuno-antioxidant response, gene expression, and histopathological investigation. Aquacult. Rep. 2022, 26, 101318. [Google Scholar] [CrossRef]
- Chukanhom, K.; Borisuthpeth, P.; Hatai, K. Antifungal activities of Aroma components from Alpinia galanga against water molds. Biocontrol Sci. 2005, 10, 105–109. [Google Scholar] [CrossRef]
- Udomkusonsri, P.; Trongvanichnam, K.; Limpoka, M.; Klangkaen, N. In vitro efficacy of the antifungal activity of some Thai medicinal-plants on the pathogenic fungus, Saprolegnia parasitica H2, from fish. Kasetsart J. (Nat. Sci.) 2007, 41, 56–61. [Google Scholar]
- Khosravi, A.R.; Shokri, H.; Sharifrohani, M.; Mousavi, H.E.; Moosavi, Z. Evaluation of the antifungal activity of Zataria multiflora, Geranium hermbarium and Eucalyptus calmadolensis essential oils on Saprolegnia parasitica-infected rainbow trout (Oncorhynchus mykiss) eggs. Foodborne Pathog. Dis. 2012, 9, 674–679. [Google Scholar] [CrossRef]
- Madrid, A.; Godoy, P.; González, S.; Zaror, L.; Moller, A.; Werner, E.; Cuellar, M.; Villena, J.; Montenegro, I. Chemical characterization and anti-oomycete activity of Laureliopsis philippiana essential oils against Saprolegnia parasitica and S. australis. Molecules 2015, 20, 8033–8047. [Google Scholar] [CrossRef] [PubMed]
- Nardoni, S.; Najar, B.; Fronte, B.; Pistelli, L.; Mancianti, F. In Vitro Activity of Essential Oils against Saprolegnia parasitica. Molecules 2019, 24, 1270. [Google Scholar] [CrossRef] [PubMed]
- Lategan, M.J.; Torpy, F.R.; Gibson, L.F. Biocontrol of saprolegnioisis in silver perch Bidyanus bidyanus (Mitchell) by Aeromonas media strain A199. Aquaculture 2004, 235, 77–88. [Google Scholar] [CrossRef]
- Lategan, M.J.; Torpy, F.R.; Gibson, L.F. Control of saprolegniosis in the eel Anguilla australis Richardson by Aeromonas media strain A199. Aquaculture 2004, 240, 19–27. [Google Scholar] [CrossRef]
- Hatai, K.; Willoughby, L.G. Saprolegnia parasitica from rainbow trout inhibited by the bacterium Pseudomonas fluorescens. Bull. Eur. Assoc. Fish Pathol. 1988, 8, 27–29. [Google Scholar]
- Bly, J.E.; Quiniou, S.M.-A.; Lawson, L.A.; Clem, L.W. Inhibition of Saprolegnia pathogenic for fish by Pseudomonas fluorescens. J. Fish Dis. 1997, 20, 35–40. [Google Scholar] [CrossRef]
- Carbajal-González, M.T.; Fregeneda-Grandes, J.M.; Suárez-Ramos, S.; Rodríguez-Cadenas, F.; Aller-Gancedo, J.M. Bacterial skin flora variation and in vitro inhibitory activity against Saprolegnia parasitica in brown and rainbow trout. Dis. Aquat. Org. 2011, 96, 125–135. [Google Scholar] [CrossRef]
- Carbajal-González, M.T.; Fregeneda-Grandes, J.M.; González-Palacios, C.; Aller-Gancedo, J.M. Adhesion to brown trout skin mucus. antagonism against cyst adhesion and pathogenicity to rainbow trout of some inhibitory bacteria against Saprolegnia parasitica. Dis. Aquat. Org. 2013, 104, 35–44. [Google Scholar] [CrossRef]
- Liu, Y.; Rzeszutek, E.; van der Voort, M.; Wu, C.-H.; Thoen, E.; Skaar, I.; Bulone, V.; Dorrestein, P.C.; Raaijmakers, J.M.; de Bruijn, I. Diversity of aquatic Pseudomonas species and their activity against the fish pathogenic oomycete Saprolegnia. PLoS ONE 2015, 10, e0136241. [Google Scholar] [CrossRef]
- Hussein, M.M.A.; Hatai, K. In vitro inhibition of Saprolegnia by bacteria isolated from lesions of salmonids with saprolegniosis. Fish Pathol. 2001, 36, 73–78. [Google Scholar] [CrossRef]
- Zhang, S.-J.; Yang, X.-L.; Li, D.; Gao, P. Screening of antagonistic bacterium strain against saprolegniosis and the preliminary study of in vitro antagonistic activity. Acta Hydrobiol. Sinica 2008, 32, 301–307. [Google Scholar] [CrossRef]
- Liu, L.-L.; Lu, F.-P.; Liu, H.; Zhou, C. Selection of antagonistic bacteria for Saprolegnia parasitica and isolation of its antibiotic protein. J. Tianjin Univ. Sci. Technol. 2011, 26, 18–21. [Google Scholar]
- Lategan, M.J.; Gibson, L.F. Antagonistic activity of Aeromonas media strain A199 against Saprolegnia sp., an opportunistic pathogen of the eel, Anguilla australis Richardson. J. Fish Dis. 2003, 26, 147–153. [Google Scholar] [CrossRef] [PubMed]
- Nurhajati, J.; Atira; Aryantha, I.N.P.; Kadek Indah, D.G. The curative action of Lactobacillus plantarum FNCC 226 to Saprolegnia parasitica A3 on catfish (Pangasius hypophthalamus, Sauvage). Int. Food Res. J. 2012, 19, 1723–1727. [Google Scholar]
- Moghaddam, A.; Hajimoradloo, A.; Ghiasi, M.; Ghorbani, R. In vitro inhibition of growth in Saprolegnia sp. isolated from the eggs of Persian Sturgeon Acipenser persicus (Pisces: Acipenseriformes) by Pseudomonas aeroginosa (PTCC: 1430). Casp. J. Environ. Sci. 2012, 11, 233–240. [Google Scholar]
- Heikkinen, J.; Tiirola, M.; Mustonen, S.M.; Eskelinen, P.; Navia-Paldanius, D.; von Wright, A. Suppression of Saprolegnia infections in rainbow trout (Oncorhynchus mykiss) eggs using protective bacteria and ultraviolet irradiation of the hatchery water. Aquac. Res. 2016, 47, 925–939. [Google Scholar] [CrossRef]
- Munir, E.; Dewi, R.; Yunasfi, Y.; Suryanto, D. A study of potential control of watermold Saprolegnia sp. of gouramy (Osphonemus gouramy) eggs by bacterial isolates. J. Pure Appl. Microbiol. 2017, 11, 623–632. [Google Scholar] [CrossRef]
- González-Palacios, C.; Fregeneda-Grandes, J.M.; Aller-Gancedo, J.M. Biocontrol of saprolegniosis in rainbow trout (Oncorhynchus mykiss Walbaum) using two bacterial isolates (LE89 and LE141) of Pseudomonas fluorescens. J. Fish Dis. 2019, 42, 269–275. [Google Scholar] [CrossRef]
- González-Palacios, C.; Fregeneda-Grandes, J.M.; Aller-Gancedo, J.M. Possible mechanisms of action of two Pseudomonas fluorescens isolates as probiotics on saprolegniosis control in rainbow trout (Oncorhynchus mykiss Walbaum). Animals 2020, 10, 1507. [Google Scholar] [CrossRef]
- Sorroza, L.; Padilla, D.; Acosta, F.; Román, L.; Grasso, V.; Vega, J.; Real, F. Characterization of the probiotic strain Vagococcus fluvialis in the protection of European sea bass (Dicentrarchus labrax) against vibriosis by Vibrio anguillarum. Vet. Microbiol. 2012, 155, 369–373. [Google Scholar] [CrossRef]
- Sorroza, I.; Real, F.; Acosta, F.; Acosta, B.; Déniz, S.; Román, I.; El-Aamri, F.; Padilla, D. A probiotic potential of Enterococcus gallinarum against Vibrio anguillarum infection. Fish Pathol. 2013, 48, 9–12. [Google Scholar] [CrossRef]
- Pérez-Sánchez, T.; Bálcazar, J.L.; García, Y.; Halaihel, N.; Vendrell, D.; De Blas, I.; Merrifield, D.L.; Ruiz-Zarzuela, I. Identification and characterization of lactic acid bacteria isolated from rainbow trout, Oncorhynchus mykiss (Walbaum), with inhibitory activity against Lactococcus garvieae. J. Fish Dis. 2011, 34, 499–507. [Google Scholar] [CrossRef]
- Fregeneda-Grandes, J.M.; Fernández-Díez, M.; Aller-Gancedo, J.M. Experimental pathogenicity in rainbow trout, Oncorhynchus mykiss (Walbaum), of two distinct morphotypes of long-spined Saprolegnia isolates obtained from wild brown trout, Salmo trutta L., and river water. J. Fish Dis. 2001, 24, 351–359. [Google Scholar] [CrossRef]
- Lategan, M.J.; Booth, W.; Shimmon, R.; Gibson, L.F. An inhibitory substance produced by Aeromonas media A199, an aquatic probiotic. Aquaculture 2006, 254, 115–124. [Google Scholar] [CrossRef]
- Hatai, K.; Hoshiai, G.I. Pathogenicity of Saprolegnia parasitica Cocker. In Salmon Saprolegniasis; Mueller, G.J., Ed.; Department of Energy. Bonneville Power Administration: Portland, OR, USA, 1994; pp. 87–98. [Google Scholar]
- Simón, R.; Docando, F.; Nuñez-Ortiz, N.; Tafalla, C.; Díaz-Rosales, P. Mechanisms used by probiotics to confer pathogen resistance to teleost fish. Front. Immunol. 2021, 12, 653025. [Google Scholar] [CrossRef] [PubMed]
- Chabrillón, M.; Rico, R.M.; Balebona, M.C.; Moriñigo, M.A. Adhesion to sole, Solea senegalensis Kaup, mucus of microorganisms isolated from farmed fish and their interaction with Photobacterium damselae subsp. piscicida. J. Fish Dis. 2005, 28, 229–237. [Google Scholar] [CrossRef]
- Balcázar, J.L.; Vendrell, D.; de Blas, I.; Ruiz-Zarzuela, I.; Muzquiz, J.L.; Girones, O. Characterization of probiotic properties of lactic acid bacteria isolated from intestinal microbiota of fish. Aquaculture 2008, 278, 188–191. [Google Scholar] [CrossRef]
- González, C.J.; Encinas, J.P.; García-López, M.L.; Otero, A. Characterization and identification of lactic acid bacteria from freshwater fishes. Food Microbiol. 2000, 17, 383–391. [Google Scholar] [CrossRef]
- Petersen, A.; Dalsgaard, A. Species composition and antimicrobial resistance genes of Enterococcus spp., isolated from integrated and traditional fish farms in Thailand. Environ. Microbiol. 2003, 5, 395–402. [Google Scholar] [CrossRef]
- Osman, K.M.; Al-Maary, K.S.; Mubarak, A.S.; Kamelia, M.; Dawoud, T.M.; Moussa, I.M.I.; Ibrahim, M.D.S.; Hessain, A.M.; Orabi, A.; Fawzy, N.M. Characterization and susceptibility of streptococci and enterococci isolated from Nile tilapia (Oreochromis niloticus) showing septicaemia in aquaculture and wild sites in Egypt. BMC Vet. Res. 2017, 13, 357. [Google Scholar] [CrossRef]
- Michel, C.; Pelletier, C.; Boussaha, M.; Douet, D.; Lautraite, A.; Tailliez, P. Diversity of lactic acid bacteria associated with fish and the fish farm environment, established by amplified rRNA gene restriction analysis. Appl. Environ. Microbiol. 2007, 73, 2947–2955. [Google Scholar] [CrossRef] [PubMed]
- Austin, B.; Austin, D.A. Bacterial Fish Pathogens: Diseases of Farmed and Wild Fish, 4th ed.; Praxis Publishing Ltd.: Chichester, UK, 2007; pp. 15–46. [Google Scholar]
- Akter, T.; Foysal, M.J.; Alam, M.; Ehsan, R.; Paul, S.I.; Momtaz, F.; Siddik, M.A.; Tay, A.C.; Fotedar, R.; Gupta, S.; et al. Involvement of Enterococcus species in streptococcosis of Nile tilapia in Bangladesh. Aquaculture 2021, 531, 735790. [Google Scholar] [CrossRef]
- Kusuda, R.; Kawai, K.; Salati, F.; Banner, C.R.; Fryer, J.L. Enterococcus seriolicida sp. nov., a fish pathogen. Int. J. Syst. Bacteriol. 1991, 41, 406–409. [Google Scholar] [CrossRef] [PubMed]
- Eldar, A.; Ghittino, C.; Asanta, L.; Bozzetta, E.; Goria, M.; Prearo, M.; Bercovier, H. Enterococcus seriolicida is a junior synonym of Lactococcus garvieae, a causative agent of septicemia and meningoencephalitis in fish. Curr. Microbiol. 1996, 32, 85–88. [Google Scholar] [CrossRef]
- Gram, L.; Løvold, T.; Nielsen, J.; Melchiorsen, J.; Spanggaard, B. In vitro antagonism of the probiont Pseudomonas flourescens strain AH2 against Aeromonas salmonicida does not confer protection of salmon against furunculosis. Aquaculture 2001, 199, 1–11. [Google Scholar] [CrossRef]
- Gram, L.; Melchiorsen, J.; Spanggaard, B.; Huber, I.; Nielsen, T.F. Inhibition of Vibrio anguillarum by Pseudomonas fluorescens AH2. a possible probiotic treatment of fish. Appl. Environ. Microbiol. 1999, 65, 969–973. [Google Scholar] [CrossRef] [PubMed]
- Zhang, L.; Xu, D.; Wang, F.; Zhang, Q.-Z. Antifungal activity of Burkholderia sp. HD05 against Saprolegnia sp. by 2-pyrrolidone-5-carboxylic acid. Aquaculture 2019, 511, 634198. [Google Scholar] [CrossRef]
- Kesacordi-Watson, A.; Kaspar, H.; Lategan, M.J.; Gibson, L. Probiotics in aquaculture: The need. principles and mechanisms of action and screening processes. Aquaculture 2008, 274, 1–14. [Google Scholar] [CrossRef]
- Pérez-Sánchez, T.; Bálcazar, J.L.; Merrifield, D.L.; Carnevali, O.; Gioacchini, G.; de Blas, I.; Ruiz-Zarzuela, I. Expression of immune-related genes in rainbow trout (Oncorhynchus mykiss) induced by probiotic bacteria during Lactococcus garvieae infection. Fish Shellfish Immunol. 2011, 31, 196–201. [Google Scholar] [CrossRef]
- Nayak, S.K. Probiotics and immunity: A fish perspective. Fish Shellfish Immunol. 2010, 29, 2–14. [Google Scholar] [CrossRef]

| Bacterial Isolate | Origin | Probiotic Activity Against | Reference |
|---|---|---|---|
| Enterococcus gallinarum L1 | Gut content of sea bass (Dicentrarchus labrax) | Vibrio angillarum in D. labrax | [31] |
| Vagococcus fluvialis L21 | Gut content of sole (Solea solea) | Vibrio angillarum in D. labrax | [30] |
| Lactobacillus plantarum subsp. plantarum CLFP3 | Cutaneous mucus of rainbow trout (O. mykiss) | Lactococcus garvieae in O. mykiss | [32] |
| Incubation Time of the Bacteria (Days) | Enterococcus gallinarum L1 | Vagococcus fluvialis L21 | Lactobacillus plantarum CLFP3 | Control Plate |
|---|---|---|---|---|
| 3 | 4.25 ± 0.05 | 5.45 ± 0.04 | 0 | 5.70 ± 0.11 |
| 5 | 3.46 ± 0.06 | 2.90 ± 0.05 | 0 | 5.17 ± 0.07 |
| 7 | 0 | 2.35 ± 0.04 | 0 | 5.65 ± 0.14 |
| Bacterial Isolate | CM | BSA | MSS | PP |
|---|---|---|---|---|
| Enterococcus gallinarum L1 | 9.92 ± 7.59 | 4.57 ± 3.48 | 3.28 ± 3.48 | 4.39 ± 2.97 |
| Vagococcus fluvialis L21 | 14.60 ± 5.48 | 7.87 ± 4.56 | 8.48 ± 3.89 | 7.98 ± 0.15 |
| Lactobacillus plantarum CLFP3 | 7.54 ± 4.77 | 4.13 ±1.31 | 4.20 ± 1.45 | 4.51 ± 0.22 |
| Bacterial Strain | Bacterial Concentration | Exclusion * | Displacement * | Competition * |
|---|---|---|---|---|
| Enterococcus gallinarum L1 | 2.5 × 107 | 28.55 ± 0.01 | 26.68 ± 2.92 | 65.03 ± 1.28 |
| 2.5 × 106 | 19.05 ± 6.73 | 24.93 ± 5.97 | 27.08 ± 3.05 | |
| 2.5 × 105 | 7.50 ± 0.01 | 18.40 ± 14.77 | 6.33 ± 1.39 | |
| 2.5 × 104 | 6.87 ± 1.89 | 0 | 6.26 ± 1.22 | |
| Vagococcus fluvialis L21 | 2.5 × 107 | 83.11 ± 1.31 | 93.24 ± 18.73 | 73.86 ± 5.55 |
| 2.5 × 106 | 62.81 ± 3.72 | 25.09 ± 9.21 | 40.03 ± 1.76 | |
| 2.5 × 105 | 55.45 ± 35.84 | 13.59 ± 9.88 | 7.39 ± 3.14 | |
| 2.5 × 104 | 17.67 ± 22.71 | 6.45 ± 4.13 | 6.49 ± 4.15 | |
| Lactobacillus plantarum CLFP3 | 2.5 × 107 | 87.50 ± 0.01 | 33.32 ± 8.14 | 33.33 ± 2.09 |
| 2.5 × 106 | 76.01 ± 6.48 | 22.30 ± 8.37 | 7.78 ± 1.45 | |
| 2.5 × 105 | 70.98 ± 8.39 | 11.05 ± 8.33 | 5.44 ± 1.44 | |
| 2.5 × 104 | 46.49 ± 17.63 | 0 | 7.29 ± 0.68 |
Disclaimer/Publisher’s Note: The statements, opinions and data contained in all publications are solely those of the individual author(s) and contributor(s) and not of MDPI and/or the editor(s). MDPI and/or the editor(s) disclaim responsibility for any injury to people or property resulting from any ideas, methods, instructions or products referred to in the content. |
© 2023 by the authors. Licensee MDPI, Basel, Switzerland. This article is an open access article distributed under the terms and conditions of the Creative Commons Attribution (CC BY) license (https://creativecommons.org/licenses/by/4.0/).
Share and Cite
Fregeneda-Grandes, J.-M.; González-Palacios, C.; Pérez-Sánchez, T.; Padilla, D.; Real, F.; Aller-Gancedo, J.-M. Limited Probiotic Effect of Enterococcus gallinarum L1, Vagococcus fluvialis L21 and Lactobacillus plantarum CLFP3 to Protect Rainbow Trout against Saprolegniosis. Animals 2023, 13, 954. https://doi.org/10.3390/ani13050954
Fregeneda-Grandes J-M, González-Palacios C, Pérez-Sánchez T, Padilla D, Real F, Aller-Gancedo J-M. Limited Probiotic Effect of Enterococcus gallinarum L1, Vagococcus fluvialis L21 and Lactobacillus plantarum CLFP3 to Protect Rainbow Trout against Saprolegniosis. Animals. 2023; 13(5):954. https://doi.org/10.3390/ani13050954
Chicago/Turabian StyleFregeneda-Grandes, Juan-Miguel, Concepción González-Palacios, Tania Pérez-Sánchez, Daniel Padilla, Fernando Real, and José-Miguel Aller-Gancedo. 2023. "Limited Probiotic Effect of Enterococcus gallinarum L1, Vagococcus fluvialis L21 and Lactobacillus plantarum CLFP3 to Protect Rainbow Trout against Saprolegniosis" Animals 13, no. 5: 954. https://doi.org/10.3390/ani13050954
APA StyleFregeneda-Grandes, J.-M., González-Palacios, C., Pérez-Sánchez, T., Padilla, D., Real, F., & Aller-Gancedo, J.-M. (2023). Limited Probiotic Effect of Enterococcus gallinarum L1, Vagococcus fluvialis L21 and Lactobacillus plantarum CLFP3 to Protect Rainbow Trout against Saprolegniosis. Animals, 13(5), 954. https://doi.org/10.3390/ani13050954

